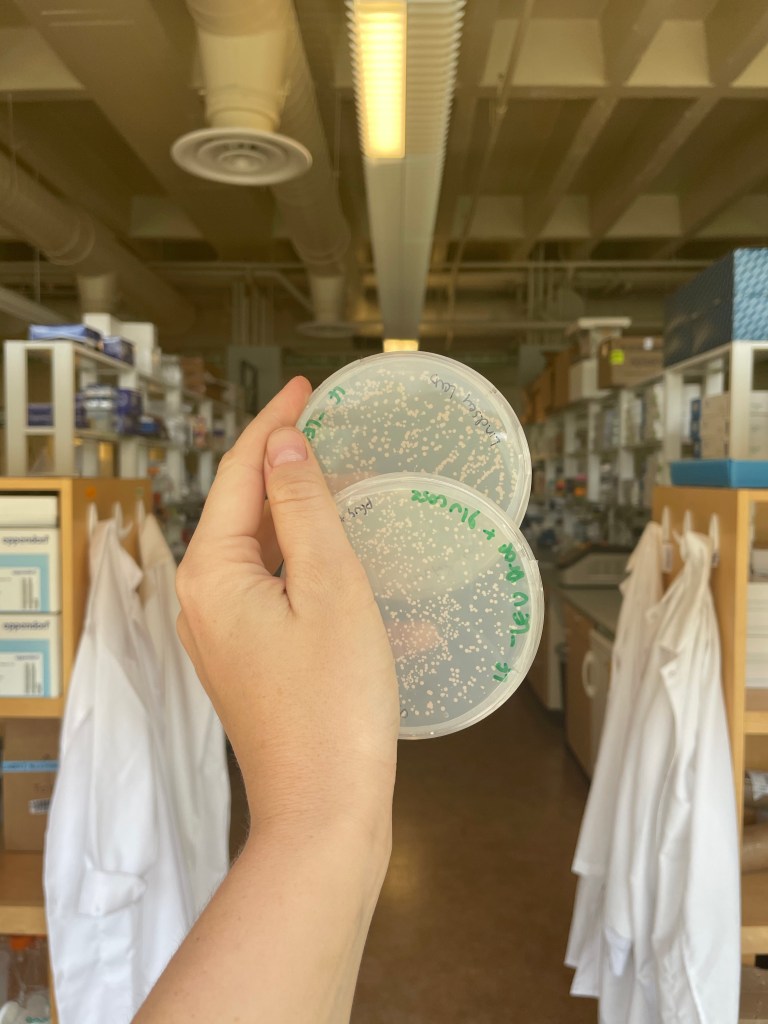

The latest (and hopefully greatest) from our group.
Science, science-adjacent, and life in Minnesota.



2025/09/26

2025/08/25

2025/08/25

2025/08/08


2025/07/15

2025/07/10


Armin Moczek & Irene Newton at Indiana University where he focused on dung beetle microbiomes.
2025/05/27